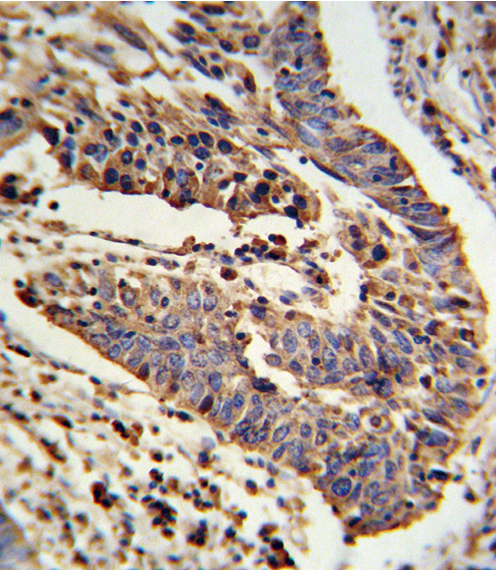
14 - SCNN1A Antibody (Center) AP8804C

SCNN1A Antibody (Center)
Affinity Purified Rabbit Polyclonal Antibody (Pab)
- 产品详情
- 实验流程
- 背景知识
Application
| IHC-P, IF, FC, WB, E |
|---|---|
| Primary Accession | P37088 |
| Reactivity | Human |
| Host | Rabbit |
| Clonality | Polyclonal |
| Isotype | Rabbit IgG |
| Calculated MW | 75704 Da |
| Antigen Region | 365-391 aa |
| Gene ID | 6337 |
|---|---|
| Other Names | Amiloride-sensitive sodium channel subunit alpha, Alpha-NaCH, Epithelial Na(+) channel subunit alpha, Alpha-ENaC, ENaCA, Nonvoltage-gated sodium channel 1 subunit alpha, SCNEA, SCNN1A, SCNN1 |
| Target/Specificity | This SCNN1A antibody is generated from rabbits immunized with a KLH conjugated synthetic peptide between 365-391 amino acids from the Central region of human SCNN1A. |
| Dilution | IHC-P~~1:100~500 IF~~1:10~50 FC~~1:25 WB~~1:2000 E~~Use at an assay dependent concentration. |
| Format | Purified polyclonal antibody supplied in PBS with 0.09% (W/V) sodium azide. This antibody is purified through a protein A column, followed by peptide affinity purification. |
| Storage | Maintain refrigerated at 2-8°C for up to 2 weeks. For long term storage store at -20°C in small aliquots to prevent freeze-thaw cycles. |
| Precautions | SCNN1A Antibody (Center) is for research use only and not for use in diagnostic or therapeutic procedures. |
| Name | SCNN1A (HGNC:10599) |
|---|---|
| Function | This is one of the three pore-forming subunits of the heterotrimeric epithelial sodium channel (ENaC), a critical regulator of sodium balance and fluid homeostasis (PubMed:30251954, PubMed:32729833, PubMed:8023962, PubMed:8278374, PubMed:9792722). ENaC operates in epithelial tissues, where it mediates the electrodiffusion of sodium ions from extracellular fluid through the apical membrane of cells, with water following osmotically (PubMed:24124190, PubMed:28710092, PubMed:8278374). It plays a key role in maintaining sodium homeostasis through electrogenic sodium reabsorption in the kidneys (PubMed:12107247). Additionally, ENaC is essential for airway surface liquid homeostasis, which is crucial for proper mucus clearance (PubMed:24124190, PubMed:28710092). |
| Cellular Location | Apical cell membrane; Multi-pass membrane protein. Cell projection, cilium. Cytoplasmic granule. Cytoplasm Cytoplasmic vesicle, secretory vesicle, acrosome {ECO:0000250|UniProtKB:P37089}. Cell projection, cilium, flagellum {ECO:0000250|UniProtKB:P37089}. Note=In the oviduct and bronchus, located on cilia in multi-ciliated cells. In endometrial non-ciliated epithelial cells, restricted to apical surfaces. In epidermis, located nearly uniformly in the cytoplasm in a granular distribution (PubMed:28130590). In sebaceous glands, observed only in the cytoplasmic space in between the lipid vesicles (PubMed:28130590). In eccrine sweat glands, mainly located at the apical surface of the cells facing the lumen (PubMed:28130590). In skin, in arrector pili muscle cells and in adipocytes, located in the cytoplasm and colocalized with actin fibers (PubMed:28130590). In spermatogonia, spermatocytes and round spermatids, located in the cytoplasm (By similarity). Prior to spermiation, location shifts from the cytoplasm to the spermatid tail (By similarity). In spermatozoa, localizes at the acrosome and the central region of the sperm flagellum (By similarity) {ECO:0000250|UniProtKB:P37089, ECO:0000269|PubMed:22207244, ECO:0000269|PubMed:24124190, ECO:0000269|PubMed:28130590} |
| Tissue Location | Expressed in the female reproductive tract, from the fimbrial end of the fallopian tube to the endometrium (at protein level) (PubMed:22207244). Expressed in kidney (at protein level). In the respiratory tract, expressed in the bronchial epithelium (at protein level). Highly expressed in lung. Detected at intermediate levels in pancreas and liver, and at low levels in heart and placenta (PubMed:22207244). in skin, expressed in keratinocytes, melanocytes and Merkel cells of the epidermal sub-layers, stratum basale, stratum spinosum and stratum granulosum (at protein level) (PubMed:28130590) Expressed in the outer root sheath of the hair follicles (at protein level) (PubMed:28130590). Detected in both peripheral and central cells of the sebaceous gland (at protein level) (PubMed:28130590). Expressed by eccrine sweat glands (at protein level) (PubMed:28130590). In skin, also expressed by arrector pili muscle cells and intradermal adipocytes (PubMed:28130590). Isoform 1 and isoform 2 predominate in all tissues |
For Research Use Only. Not For Use In Diagnostic Procedures.
Provided below are standard protocols that you may find useful for product applications.
BACKGROUND
Nonvoltage-gated, amiloride-sensitive, sodium channels control fluid and electrolyte transport across epithelia in many organs. These channels are heteromeric complexes consisting of 3 subunits: alpha, beta, and gamma. This gene encodes the alpha subunit, and mutations in this gene have been sociated with pseudohypoaldosteronism type 1 (PHA1), a rare salt wasting disease resulting from target organ unresponsiveness to mineralocorticoids.
REFERENCES
Azad A.K., et.al., Hum. Mutat. 30:1093-1103(2009).
终于等到您。ABCEPTA(百远生物)抗体产品。
点击下方“我要评价 ”按钮提交您的反馈信息,您的反馈和评价是我们最宝贵的财富之一,
我们将在1-3个工作日内处理您的反馈信息。
如有疑问,联系:0512-88856768 tech-china@abcepta.com.























 癌症的基本特征包括细胞增殖、血管生成、迁移、凋亡逃避机制和细胞永生等。找到癌症发生过程中这些通路的关键标记物和对应的抗体用于检测至关重要。
癌症的基本特征包括细胞增殖、血管生成、迁移、凋亡逃避机制和细胞永生等。找到癌症发生过程中这些通路的关键标记物和对应的抗体用于检测至关重要。 为您推荐一个泛素化位点预测神器——泛素化分析工具,可以为您的蛋白的泛素化位点作出预测和评分。
为您推荐一个泛素化位点预测神器——泛素化分析工具,可以为您的蛋白的泛素化位点作出预测和评分。 细胞自噬受体图形绘图工具为你的蛋白的细胞受体结合位点作出预测和评分,识别结合到自噬通路中的蛋白是非常重要的,便于让我们理解自噬在正常生理、病理过程中的作用,如发育、细胞分化、神经退化性疾病、压力条件下、感染和癌症。
细胞自噬受体图形绘图工具为你的蛋白的细胞受体结合位点作出预测和评分,识别结合到自噬通路中的蛋白是非常重要的,便于让我们理解自噬在正常生理、病理过程中的作用,如发育、细胞分化、神经退化性疾病、压力条件下、感染和癌症。